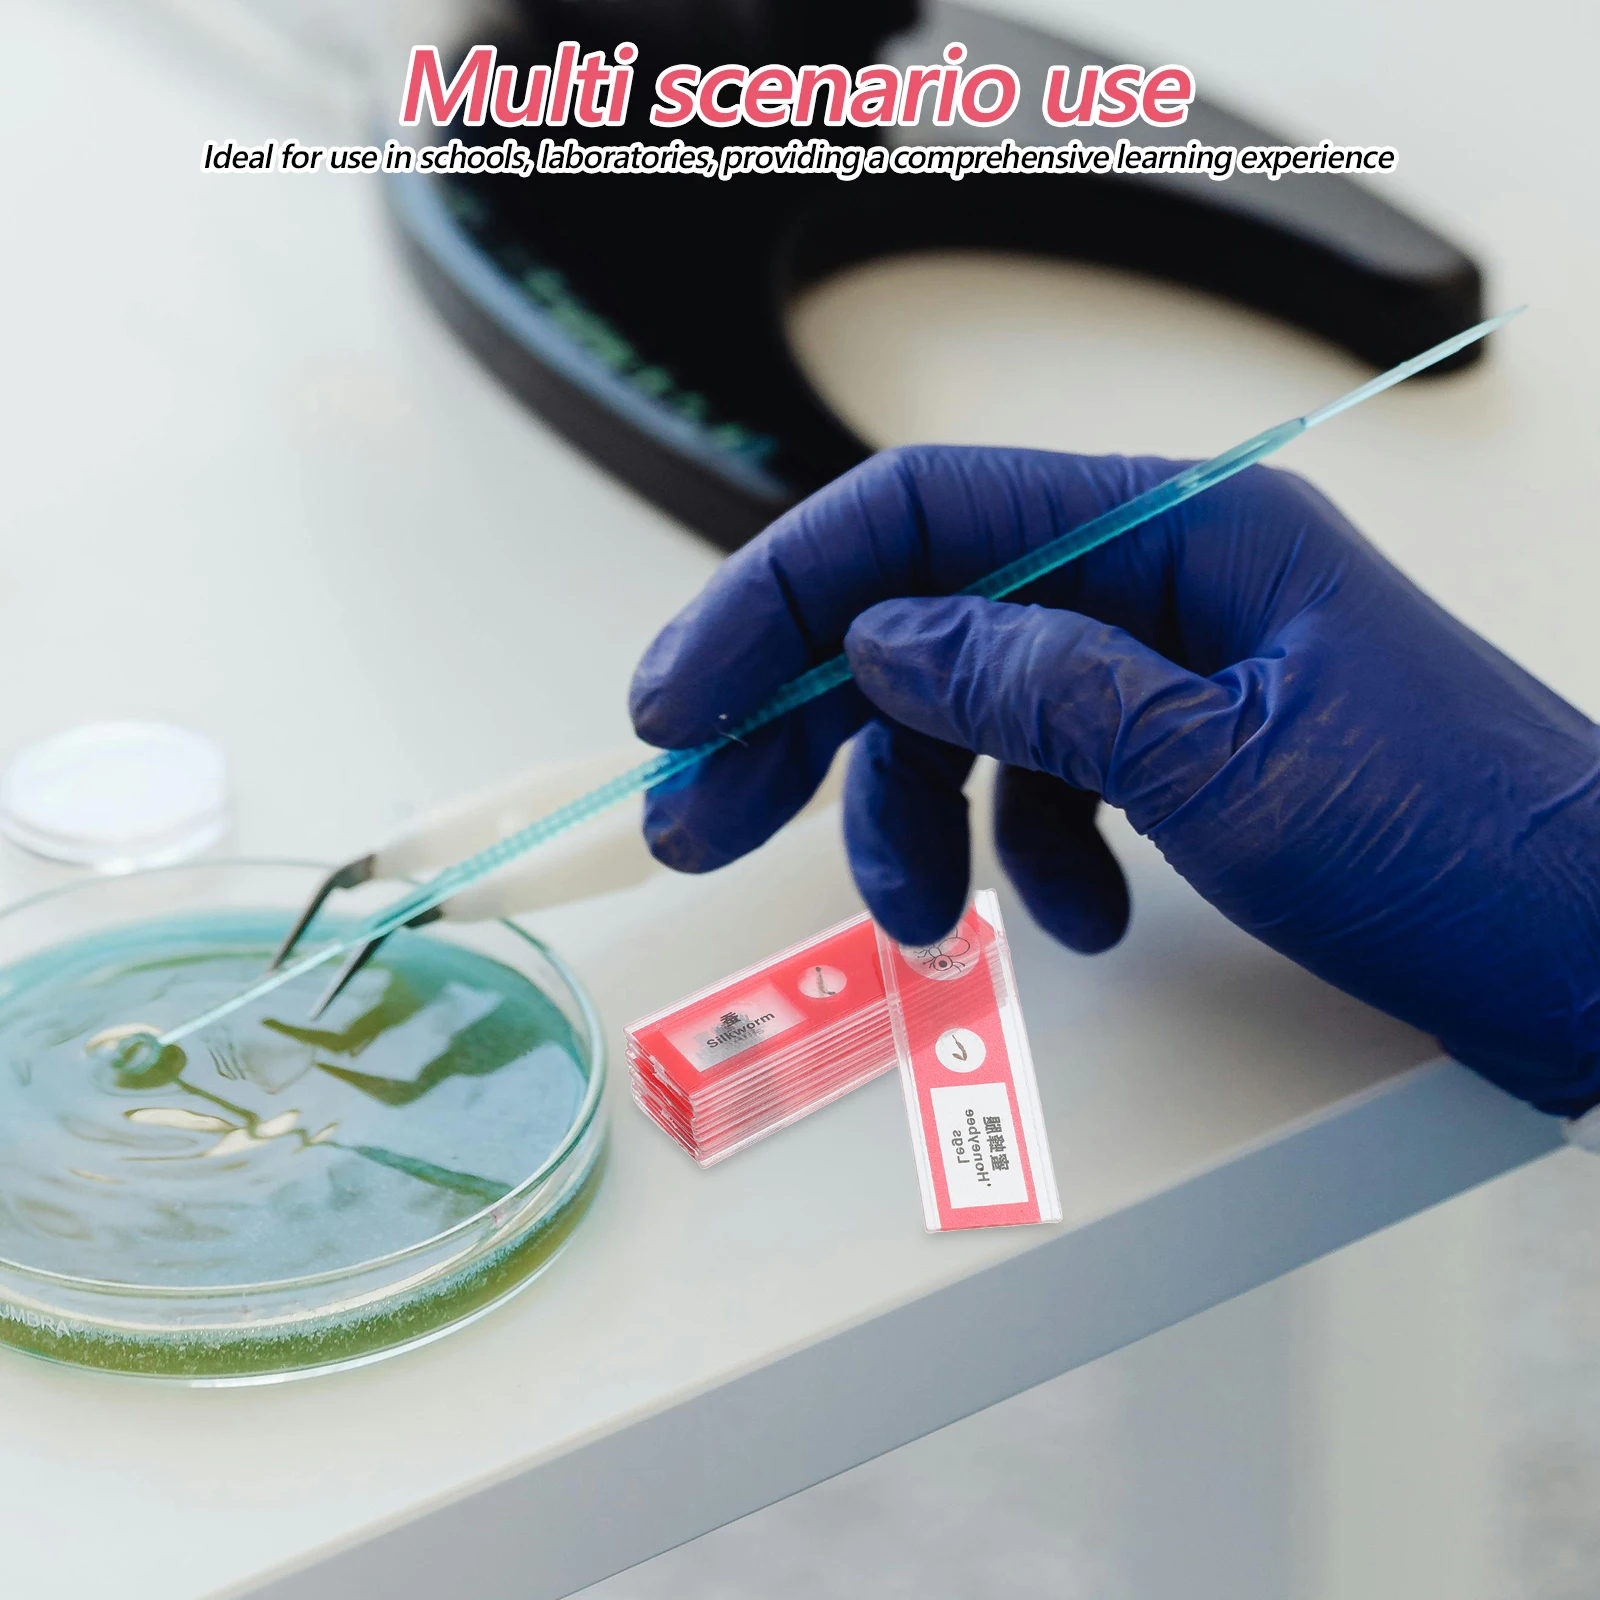

Ультратонкий жесткий пластиковый чехол с металлическим кольцом для Samsung Galaxy Z Flip 3













sku: 1005003463340742
ACCORDING TO OUR RECORDS THIS PRODUCT IS NOT AVAILABLE NOW
$10.80
Shipping from: China
Technical Details
commissionRate: | 6.92% |
discount: | 40% |
Price history chart & currency exchange rate
Customers also viewed

$31.66
men's fashion designer offs t shirts luxury cotton loose t-shirts casual summer short sleeves oil painting black back print arrow women, White;black
dhgate.com
$70.35
summer new brand men's denim shorts fashion hole patch patches elastic casual slim d2 short jeans streetwear, Blue
dhgate.com
$59.81
Новинка 2022, зимняя длинная куртка Lagabogy, Женское пальто на молнии с 90% белым утиным пухом, Женская Толстая теплая парка, зимняя повседневная в...
aliexpress.ru
$24.60
2023 модные джинсы, мужские осенние однотонные корейские свободные уличные мужские повседневные Высококачественные широкие джинсы, Длинные ...
aliexpress.ru
$22.40
2 Pcs Adhesive Mural Wall Sticky Retro Door Wallpaper 3D Door Stickers Appliques Embellishments Peeling Vinyl Door Mural
aliexpress.ru
$11.62
Форсунка щетки стеклоочистителя Омыватель лобового стекла автомобилей пластиковый 2PIN 8J0955987G прямой монтаж Высокое качество быстрое восста...
aliexpress.ru
$48.99
Новинка IP68 Водонепроницаемые Смарт-часы женский милый браслет монитор сердечного ритма мониторинг сна
aliexpress.ru
$31.54
Автоматический горшок для полива растений, керамический садовый горшок для выращивания цветов в помещении
aliexpress.ru
$19.90
Губная помада, новинка 2022, темпераментный разноцветный блеск для губ, блеск для губ с белыми секундами, зеркальная глазурованная губная пом...
aliexpress.ru
$26.77
Новинка, женская одежда, осень 2022, приталенный пуловер с V-образным вырезом и перекрестными пуговицами, вязаная рубашка, свитер с длинными ру...
aliexpress.ru
$64.60
Дизайнерские брендовые короткие сапоги на платформе для женщин, эластичные повседневные женские сапоги с золотыми заклепками, рыцарские с...
aliexpress.ru
$350.00
CR MATCHX M2PRO MXC BTC DHX Miner версия для ЕС 868 МГц! Макс. 6 ватт. Невероятно!
aliexpress.ru
$122.29
women luxurys designers shoulder bags luxury brand food basket bucket bag fashion simple women's designer real leather handbags 1216 zh
dhgate.com
$27.59
Smart Ultrasonic Cleaner Anti-Slip Stainless Steel Ultrasound Wave Washing for Jewelry Glasses Watch Ultrasound Bath Machine EU
aliexpress.com
$10.14
Sudadera con capucha y estampado 3D para niños y mujeres, ropa de calle moderna, jersey de manga larga, chaqueta fresca, otoño
aliexpress.com
$16.29
Одеяла с зеленым чаем Аризона, одеяла для девочек и мальчиков, Детские фланелевые украшения для спальни
aliexpress.com
$5.99
Flip Real Leather Tablet Case For Apple iPad Air3 Pro 10.5 inch Kickstand Smart Cover Coque ipad Air 3 Pro 10.5 Cases Fundas
aliexpress.com
$23.84
women boho long maxi dress lady a line party evening summer beach sundress sleeveless polka dot holiday dress, Black;gray
dhgate.com
$4.12
For Xiaomi Redmi 5A Case azns Hight Quality PU Leather Stand Case Book Flip Style Mobile Phone Cases
aliexpress.com
$1.21
Mtssii 15ml Acrylic Poly Gel Pink White Clear Crystal UV LED Builder Gel Tips Enhancement Slip Solution Quick Extension Gel
aliexpress.com
$72.44
Coffee table rock slab coffee table living room household rectangular Internet celebrity small coffee table
aliexpress.com
$12.33
12 Rolls Pearl Luster Sticky Ball Tape Adhesive Colored Fidget Toys Plastic Child Stress Relief DIY Craft Decorative
aliexpress.com
$1,484.10
China Top Sales Waterjet High Pressure Cutter Spare Parts 05034772 Cylinder Head End bell
aliexpress.com
$2.42
Spool With Line For Ryobi RLT5027 RLT5127 RLT5030S RLT5030SG RLT6030 RY41140 Ryno YT5238 Toro 51480 31104178G RAC123 AC41RDLA
aliexpress.com
$3.72
1 Set Blank Pencil Pouch Multi-Functional Bag Portable Stationery Storage Diy Pen Container Canvas Zipper Design For
aliexpress.com
$1.71
Plastic Bottle 500ml Small Mouth Round Lab Containers Leak Proof Sealed Mini Bottles Liquid Storage Sample Bottle For Solvent
aliexpress.com
$12.22
people are particularly stupid today blue T-Shirt man clothes Short sleeve tee anime tshirt men t shirts high quality
aliexpress.com
$45.62
Anime Cosplay Cosplay Zenin -Mai Cosplay Costume Zenin Mai Cosplay Halloween Costume Fancy cosplay
aliexpress.com
$3.33
2 Pcs Staple Remover Home Office Accessories Marbling Hand Stapler Heavy Duty Removal Tools
aliexpress.com
$1.27
Jazz Dance Crutches Children Cosplay Cane Golden Halloween Prop Supplies Walking Stick Costume Accessory Performance Stage
aliexpress.com
$1.63
12 Pcs Biological Sample Sections Microscope Samples Animal Slide Sampler Insect Slides Biology Collection Plastic Assortment
aliexpress.com